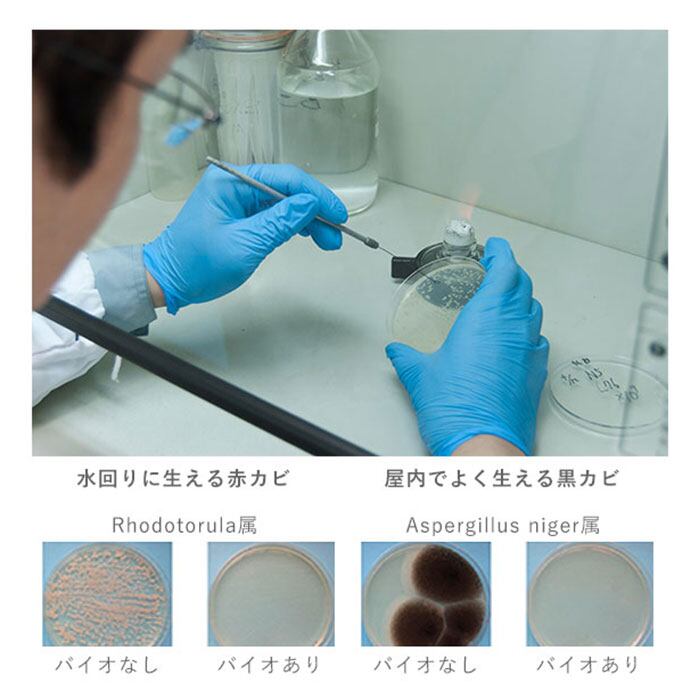

バイオラボ biolabo お風呂 防カビ 通販 2個セット ステッカー 貼るだけ 消臭 消臭ステッカー カビ対策 カビ防止 掃除 清潔 シンプル お風呂用 ウォールケースバス Wall Case Bath バス デザイン
¥2,156 税込
SOLD OUT
この商品は送料無料です。
【ブランド名】
biolabo(バイオラボ)
【商品名】
biolabo バイオラボ BL19 Wall Case Bath 2個セット
【商品説明】
・お風呂や水回りに貼るだけで防カビ&消臭!ウォールケースバス 2個セットが新登場。
・ケース裏面のシールで浴室の壁などに貼りつけるだけ♪
・バイオが放つ抗菌性の揮発性物質がカビの繁殖を防ぎ、気になるニオイを吸収・分解して消臭!
・揮発性物質は下に流れていくので、天井など壁の高いところに貼ることで効果が高まる◎
・自然から生まれるバイオは人と地球に優しく、安心・安全。
・交換目安は約6ヶ月!使用開始日を記載できる、DATEシールが付属。
・コンパクトなサイズ感とシンプルなデザインも魅力♪
【素材】
[ケース]プラスチック
※[付属品]DATEシール
【生産国】
日本
【サイズ】
[縦]約7.5cm/[横]約7.5cm/[奥行]約2cm
※サイズは当店計測の実寸サイズです。実際の商品ならびにメーカー表記サイズとは多少の誤差が生じる場合がございます。あらかじめご了承ください。
【重量】
約23g
【成分】
微生物(バチルス属)、無機パーライト
【使用方法】
1.ケースを貼る箇所の汚れをきれいに取ります。
2.ケース本体裏面のシール保護紙をはがし、ケース本体の中心を押さえるようにして貼り付けてください。
3.付属のステッカーに、貼った日付を油性ペンなどで記入し、本体に貼付けて交換時期の目安にしてください。
※揮発性物質は下に流れるため、壁の高いところや、天井に貼ると効果が高まります。
【注意点】
[有効期間]約6ヶ月
※本来の用途以外でのご使用はお避けください。
※アイコンが示すおふろや水回りでご使用ください。
※本品はカビの抑制を目的とするものです。カビの色素はとれません。
※使用環境が著しく汚れている場合は、効果が現れるのに時間がかかります。
※使用環境によっては有効期限が異なる場合があります。
※本品に直接水をかけないでください。
※本品設置中に強酸・強いアルカリ性洗剤や塩酸系の薬品等を使用されますとバイオが死滅する恐れがあるため、ご使用をお避けください。
※開封時、製品特有の臭いがする場合がございますが、使用するにつれ臭いは薄まります。
※浴室乾燥機、暖房機の吹出し口周辺には設置しないでください。
※磨りガラス、凹凸がある面、汚れ防止加工等を施した壁面ではご使用できません。
※本品をはがす際は、ゆっくり丁寧にはがしてください。壁面の素材によっては破損する恐れがございます。
※本品開封前の保管は直射日光のあたる場所を避け、乳幼児の手の届かない所で保管してください。
※使用後、破棄する際はお住まいの自治体のルールに従ってください。
※カメラやモニターの性質により、画像と実物の色の違いがある場合がございますのでご理解願います。
このショップでは酒類を取り扱っています。20歳未満の者の飲酒は法律で禁止されています。
-
レビュー
(789)
-
送料・配送方法について
-
お支払い方法について
¥2,156 税込
SOLD OUT